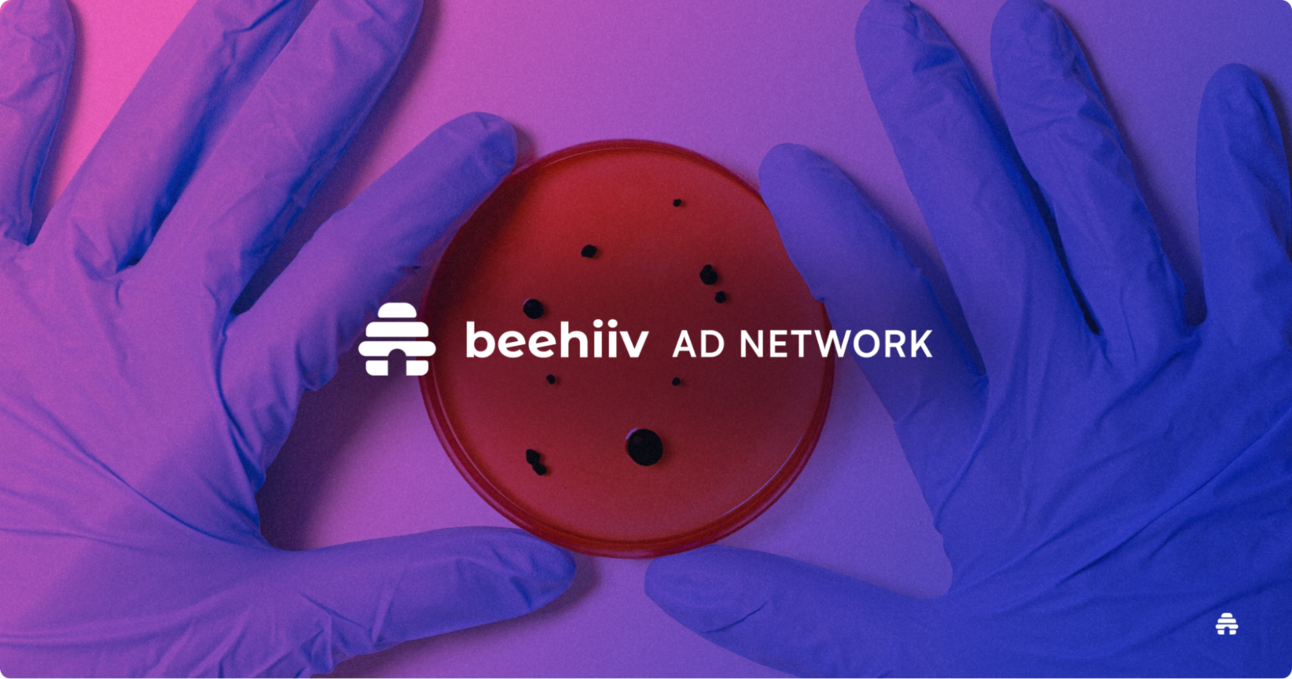

Jake Schonberger
76 articles

Ad Network Spotlight: How Your Extra Paycheck Earns Passive Income
How Chris Myles Has Landed Over 12+ Sponsors With beehiiv

Top Arts and Culture Newsletters to Sponsor
Reach Creatives and Culture Enthusiasts Through These Must-Read Newsletters

Top Cosmetics & Skincare Newsletters to Sponsor
Reach Beauty Enthusiasts and Skincare Experts Through These Must-Read Newsletters

Why Starglow's Ad Model Make Quality Parenting Advice Available to All
How One Company Built a Screen-Free Movement Through Weekly Guidance

Why Fabien Brl Calls beehiiv Ad Network a "Must-Have" for Growth
Why SaaS Elite Academy Chose beehiiv To Fuel Its Growth Strategy

Why Newsletter Advertising is More Effective Than Social Media Ads
How to Choose the Right Newsletter for Your Brand Sponsorship

10 Photography Newsletters You Need to Sponsor
From Camera Gear Reviews to Creative Tips for Photographers

10 Book and Literature Newsletters You Need To Sponsor
From Book Recommendations to Productivity Hacks

How Leaders of Today Made $2000+ With Just a Few Clicks
Earn Revenue by Leveraging the beehiiv Ad Network
Top 10 Science Newsletters to Sponsor in 2024: Elevate Your Brand with Targeted Ad Placements
Connect with Curious Minds: The Ultimate Guide to Sponsoring Science Newsletters for Maximum Impact

How To Boost Your Newsletter Revenue in Just 3 Months With beehiiv
Why Newsletter Creators Are Flocking to beehiiv for Easy Monetization

Top 9 Digital Marketing Newsletters to Sponsor in 2024
Unlock the Power of Niche Marketing by Sponsoring these High-Impact Digital Marketing Newsletters

Ad Network Case Study: The Money Buzz’s Easy Income Stream
How The Money Buzz Newsletter Earns Semi-Passive Income

Top 10 Renewable Energy Newsletters to Sponsor
The Ultimate Guide to Renewable Energy Newsletters: Amplify Your Green Initiatives and Connect with Eco-Conscious Readers

beehiiv Ad Network: How James Miller Monetized in One Month
How James Miller Monetized Effortlessly in One Month

Essential Retail and E-Commerce Newsletters for 2024
Stay Ahead of Retail Trends and Innovations: Must Sponsor Newsletters for the Modern Retailer

How Stay Ahead in AI Increased Engagement With beehiiv Ad Network
Why the Secret To Engaging Audiences in the AI Realm Is With beehiiv

Top Human Resources Newsletters to Sponsor
Essential HR Newsletters for Staying Ahead in Talent Management and Workplace Innovation

The MilSpo Minute: Earning Easy Revenue With the beehiiv Ad Network
How This Military Spouse Newsletter Is Tapping Into beehiiv’s Revenue Stream

Top 10 Consumer Tech Newsletters beehiiv You Need To Sponsor
Maximize Your Reach with the Best Consumer Tech Newsletters on beehiiv

How Captain Yar Generated a $40,000 Newsletter in Just 6 Months
Why Captain Yar Recommends the beehiiv Ad Network to All Newsletter Operators

Top 10 FinTech Newsletters You Need to Sponsor
Stay Updated on FinTech Innovations: The Best Newsletters to Follow and Sponsor

The Creator’s Den: Earning Repeat Revenue With the beehiiv Ad Network
How This AI Newsletter Is Tapping Into New Revenue Streams

Top 10 Automotive Newsletters on beehiiv You Need to Sponsor
Stay Ahead in the Auto Industry: The Best Newsletters to Follow and Sponsor

How beehiiv fuels From X to Tech's Monetization Engine
How Creators are Cashing in with beehiiv Ads and Boosts

Top 10 Newsletters about Startups on beehiiv You Need To Sponsor
Connect with Innovators by Sponsoring the Top beehiiv Startup Newsletters

Top 9 Software Engineering Newsletters on beehiiv You Need To Sponsor
Drive Engagement by Sponsoring These Leading Software Engineering Newsletters

How AdQuick Drove Positive ROI via the beehiiv Ad Network
How AdQuick's B2B Marketing Success With beehiiv Led To Advertising Mastery

Top Food and Beverages Newsletter You Should Be Sponsoring
Your Go-To Newsletter For Recipies, Latest Food Trends, and So Much More!

10 Creator Newsletter on beehiiv You Should Sponsor
These Creator Newsletters Are at the Top of Their Game in This Ever-Evolving Space

How AI Fire earned $1000’s in incremental revenue from the Ad Network
AI Fire's Winning Strategy with beehiiv Ad Network

Top 11 beehiiv Newsletters Every Real Estate Enthusiast Should Sponsor
Stay Ahead in the Real Estate Market with These Essential Newsletters

How The Daily Coach Increased Revenue With the beehiiv Ad Network
How This Daily Newsletter For Sports Leaders Is Growing Its Revenue

Top 10 Media and Entertainment Newsletters You Should Be Sponsoring
Be It Television or Creator Economy, These Newsletters Will Be Your Go To

10 Crypto Newsletters You Should Be Sponsoring
Crypto Updates to Regulations, These Newsletters Cover Them All

Top 9 Gaming Newsletters You Should Be Sponsoring
From News Updates To Gaming Updates, These Newsletters Will Be Your Go-To!

Top 10 Fashion Newsletters You Need to Sponsor
From Sneakers To Vintage, This List Has It All!

Why the Rundown Founder Says the beehiiv Ad Network Is the Best Newsletter Growth Channel
How the beehiiv Ad Network Is a Game Changer For Publishers

Top 10 Education & Career Newsletters You Need To Sponsor
From Skill Development Tools to Industry Trends, These Newsletters Cover Them All!

10 Must-Subscribe Newsletters if You’re a Tech Enthusiast
Stay Informed and Inspired with These Tech Newsletter Gems

Top 10 Travel Newsletters to Fuel Your Wanderlust
Expert Insights and Insider Tips for Your Next Adventure

Top 10 Fitness Newsletters to Crush Your Goals
The latest trends and expert advice to elevate your fitness journey, all delivered to your inbox.

How Xembly Increased Qualified Leads and Site Visitors With beehiiv
Learn how the beehiiv Ad Network saved Xembly 40 hours/month while driving high quality leads

Top 11 Wellness and Fitness Newsletters of 2024
For the Latest Insights and Tips for a Healthier Lifestyle

How Growth Daily Decreased CAC by 30% With the beehiiv Ad Network
How One Marketing Legend Tapped Into beehiiv’s Ad Network To Grow

10 beehiiv AI News Newsletters That Should Be On Your Radar for 2024
Discover the Top 10 AI Newsletters for 2024





























